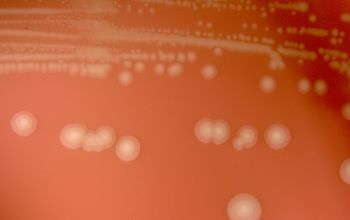

Haemophilus influenzae
-
General information
H.influenzae was first described in 1892 by Richard Pfeiffer during an influenza pandemic.
The bacterium was mistakenly considered to be the cause of influenza until 1933 when the viral etiology of influenza became apparent.
Taxonomy
Family: Pasteurellaceae
H.influenzae 2 types
- unencapsulated
- encapsulated ► capsular antigens type (a-f)
The most virulent strain is H. influenzae type b (Hib)
Their capsule allows them to resist phagocytosis.
The unencapsulated strains are almost always less invasive; they can, however, produce an inflammatory response in humans, which can lead to many symptoms.
Natural habitats
H. influenzae belongs to the normal flora of the nasopharynx, but rarely in the oral cavity.
They may be present in the vaginal flora.
It is usually the non-encapsulated strains that are harbored as normal flora, but a minority of healthy individuals harbor H. influenzae type b (Hib) encapsulated strains in the upper respiratory tract.
These strains are opportunistic pathogens; that is, they usually live in their host without causing disease, but cause problems only when other factors (such as a viral infection, reduced immune function or chronically inflamed tissues, e.g. from allergies) create an opportunity.
Clinical significance
Naturally acquired disease caused by H. influenzae seems to occur in humans only.
In infants and young children.
H. influenzae type b (Hib) causes bacteremia, pneumonia, epiglottitis and acute bacterial meningitis.
On occasion, it causes cellulites, osteomyelitis, and infectious arthritis.
Vaccination
with Hib conjugate vaccine is effective in preventing Hib infection, but does not prevent infection with unencapsulated strains
-
Diseases
-
Gram stain
Small, pleomorphic Gram negative rods
0.2-0.3 x 0.5-0.8 µm,
may range from coccobacilli to filamentous rods.
Elongated forms from sputum may exhibit bipolar staining, leading to an erroneous diagnosis of S. pneumoniae
-
Culture characteristics
-
Facultative anaerobic
5% CO2 improves the growth and requirements for X and/or V factors for growth
BA: no growth,
Growth is only achieved as a satellite phenomenon around a S. aureus.
CHOC-agar: (present in X- and V-factor)
Colonies are smooth, with a flat or convex shape.
They are nonpigmented (i.e., buff or light tan) or slightly yellow and are 0.5 to 2.0 mm in diameter.
McConkey: no growth
BBAØ: growth
Satellite
H. influenzae will grow in the hemolytic zone of S. aureus on blood agar plates, the hemolysis of cells by S. aureus releases factor V which is needed for its growth.
H. influenza will not grow outside the hemolytic zone of S. aureus due to the lack of nutrients such as V-factor in these areas.
CHOC-agar:
The heat releases X- (hemin) and V (NAD or NADP) factor from the red blood cells, and turns the medium in a chocolate brown color.
-
-
Characteristics
-
References
James Versalovic et al.(2011) Manual of Clinical Microbiology 10th Edition
Karen C. Carrol et al (2019) Manual of Clinical Microbiology, 12th Edition